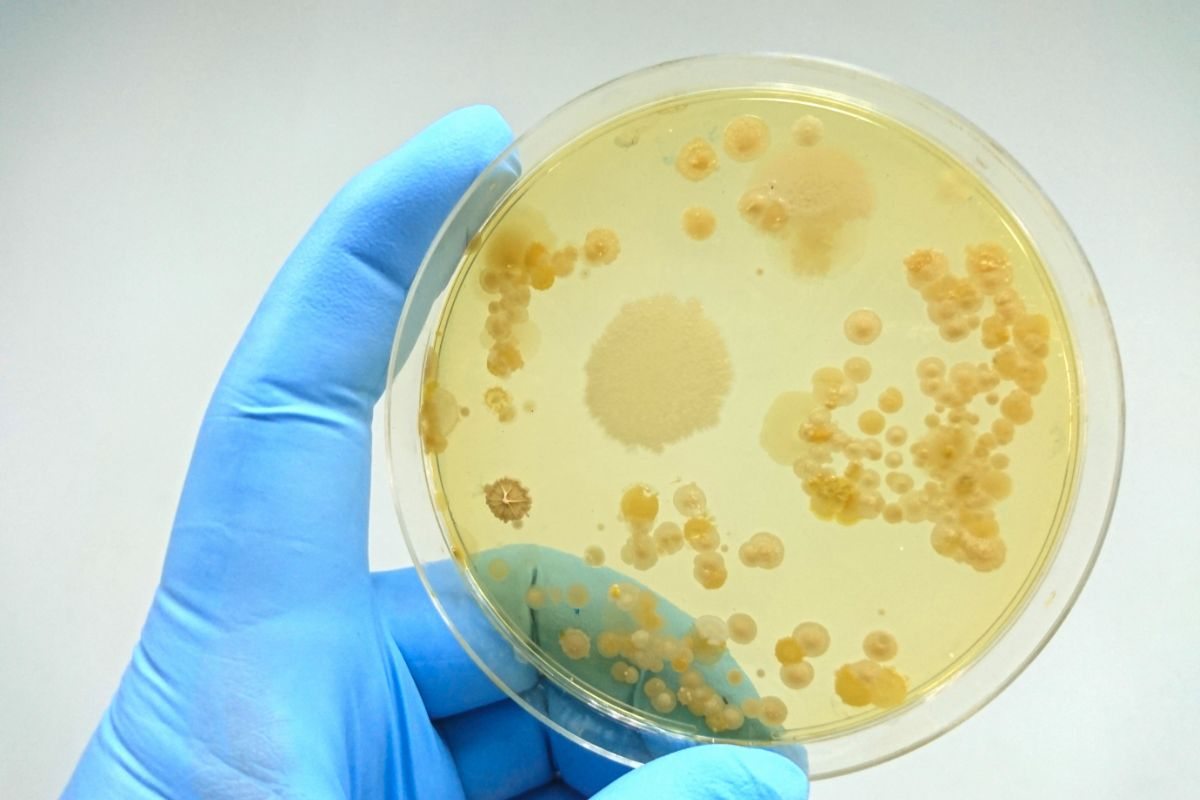
vetrino con colonia di batteri

Li usiamo tutti i giorni eppure questi oggetti non vengono mai puliti come dovrebbero: in poco tempo diventano un vero covo di germi e batteri.
Quando pensiamo alle pulizie di casa, ci vengono subito in mente pavimenti, bagno, cucina e polvere sui mobili. Ma ci sono oggetti e superfici che, seppur invisibili o apparentemente puliti, accumulano sporco, germi e batteri senza che ce ne accorgiamo. Nonostante li maneggiamo ogni giorno, spesso dimentichiamo completamente di pulirli, facendoli diventare un vero pericolo.
Mantenere una casa perfettamente pulita ed igienizzata sicuramente non è un compito facile, soprattutto se non abbiamo abbastanza tempo da dedicare. Inoltre, c’è anche un’aggravante, ossia che ci sono alcuni oggetti, che, nonostante vengano usati ogni giorno non puliamo mai, facendoli diventare un vero covo di germi e batteri.
Questi oggetti andrebbero puliti ogni giorno: sono un vero covo di germi e batteri
Maneggiar ogni giorno oggetti che in apparenza sembrano puliti anche se in realtà non lo sono, può sottoporci a dei rischi anche piuttosto seri. Ecco perché è importante conoscere quali sono queste cose che necessitano di una pulizia accurata per eliminare tutto lo sporco che accumulano.

Ecco una lista (con qualche sorpresa) di cose che probabilmente non abbiamo mai pensato di dover pulire… e che invece dovremmo iniziare a fare sin da subito:
- Telecomando: sì, proprio lui. Sempre tra le mani, sul divano, a volte anche a tavola. È uno degli oggetti più toccati in casa e raramente pulito. Basta un panno con alcol isopropilico o salviette igienizzanti. Ogni quanto farlo? Almeno una volta a settimana, soprattutto se ci sono bambini;
- Maniglie delle porte e gli interruttori: vengono toccati ogni giorno da tutte le mani di casa, spesso anche quando rientriamo da fuori. Eppure, nella maggior parte delle routine di pulizia, vengono ignorati. Basterà pulirli una volta a settimana, oppure ogni 2-3 giorni in inverno o in caso di raffreddori;
- Spazzola per capelli: quanta polvere e quanta pelle morta si accumulano tra i denti della spazzola? Rimuovere i capelli ogni giorno e lavarla ogni due settimane con acqua calda e shampoo servirà ad averla sempre pulita ed igienizzata;
- Caricatore del telefono: attenzione però, non il filo, ma la testina che entra nella presa. Accumula polvere e talvolta grasso, soprattutto se la tocchiamo con le mani unte o sporche. Pulirla in modo adeguato una volta al mese, con un cotton fioc asciutto o leggermente umido.
Ecco che quindi, questi sembrano essere gli oggetti più sporchi che abbiamo in casa e che non puliamo mai, nonostante il loro utilizzo quotidiano.












